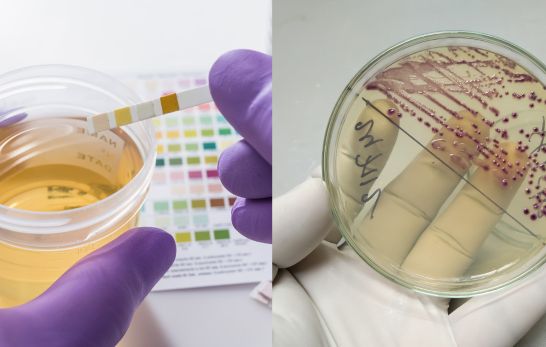
Urinkontrolle im Vergleich zur Harnkultur

Kategorie: Labor - Urinkontrolle, Urinfarben und Uringerüche
Urinkontrolle und Harnkultur sind Schlüsselaspekte der medizinischen Diagnostik: Urintests erkennen schnell Anomalien, während Harnkulturen Infektionserreger identifizieren. Unterschiedliche Uringerüche sind oft harmlos und resultieren aus Ernährung oder Medikamenten. Die Farbe des Urins bietet wertvolle Hinweise auf die Gesundheit - unser Ratgeber klärt auf, welche Farben ärztliche Aufmerksamkeit erfordern.
- Details
- IKS e.V.
- Kategorie: Labor - Urinkontrolle, Urinfarben und Uringerüche
- Lesezeit: 3 Minuten
- Zugriffe: 479
Gesundheitsanalysen sind ein wesentlicher Bestandteil der medizinischen Diagnostik und Prävention. Insbesondere bei der Untersuchung von Harnwegsinfektionen und anderen Nierenproblemen sind Urintests ein unverzichtbares Werkzeug. Dabei wird häufig zwischen zwei grundlegenden Untersuchungsmethoden unterschieden: der Urinkontrolle und der Harnkultur. Beide Methoden haben spezifische Ziele und bieten unterschiedliche Informationen über den Gesundheitszustand des Patienten. In diesem Artikel beleuchten wir die Unterschiede, Anwendungsbereiche und Bedeutungen von Urinkontrolle und Harnkultur.
- Details
- IKS e.V.
- Kategorie: Labor - Urinkontrolle, Urinfarben und Uringerüche
- Lesezeit: 4 Minuten
- Zugriffe: 1614
Der Geruch des Urins kann vielfältige Ursachen haben und wird von zahlreichen Faktoren beeinflusst. Urin ist ein Abfallprodukt des Körpers, das hauptsächlich aus Wasser, aber auch aus Abbauprodukten von Nahrungsmitteln, Medikamenten, und anderen Substanzen besteht. Veränderungen im Geruch des Urins können durch physiologische Veränderungen, Ernährung, Hydratationsniveau, Gesundheitszustand und andere externe Faktoren verursacht werden. Im Folgenden werden die wichtigsten Ursachen für unterschiedliche Uringerüche detailliert erläutert.
Weiterlesen: Wie kommt es zu unterschiedlichen Uringerüchen?
- Details
- IKS e.V.
- Kategorie: Labor - Urinkontrolle, Urinfarben und Uringerüche
- Lesezeit: 2 Minuten
- Zugriffe: 573
Die Farbe des Urins ist ein wertvoller Indikator für Ihre Gesundheit. Normale Urinfarben reichen von klar bis blassgelb, aber auch andere Farben können auftreten und auf verschiedene gesundheitliche Zustände hinweisen. Hier erklären wir, was die unterschiedlichen Urinfarben bedeuten und wann ein Arztbesuch ratsam ist.
- Details
- IKS e.V.
- Kategorie: Labor - Urinkontrolle, Urinfarben und Uringerüche
- Lesezeit: 4 Minuten
- Zugriffe: 524
Der Prostata-spezifische Antigen-Wert (PSA-Wert) ist ein bedeutender Laborparameter in der Urologie, der zur Früherkennung, Diagnose und Überwachung von Erkrankungen der Prostata verwendet wird. Der PSA-Wert gibt die Konzentration des Enzyms Prostata-spezifisches Antigen im Blut an, einer Substanz, die von der Prostata produziert wird. Im Folgenden wird die Bedeutung des PSA-Werts im Kontext der Prostata detailliert erläutert.
Weiterlesen: PSA-Test - Prostata-spezifische Antigen-Wert (PSA-Wert)